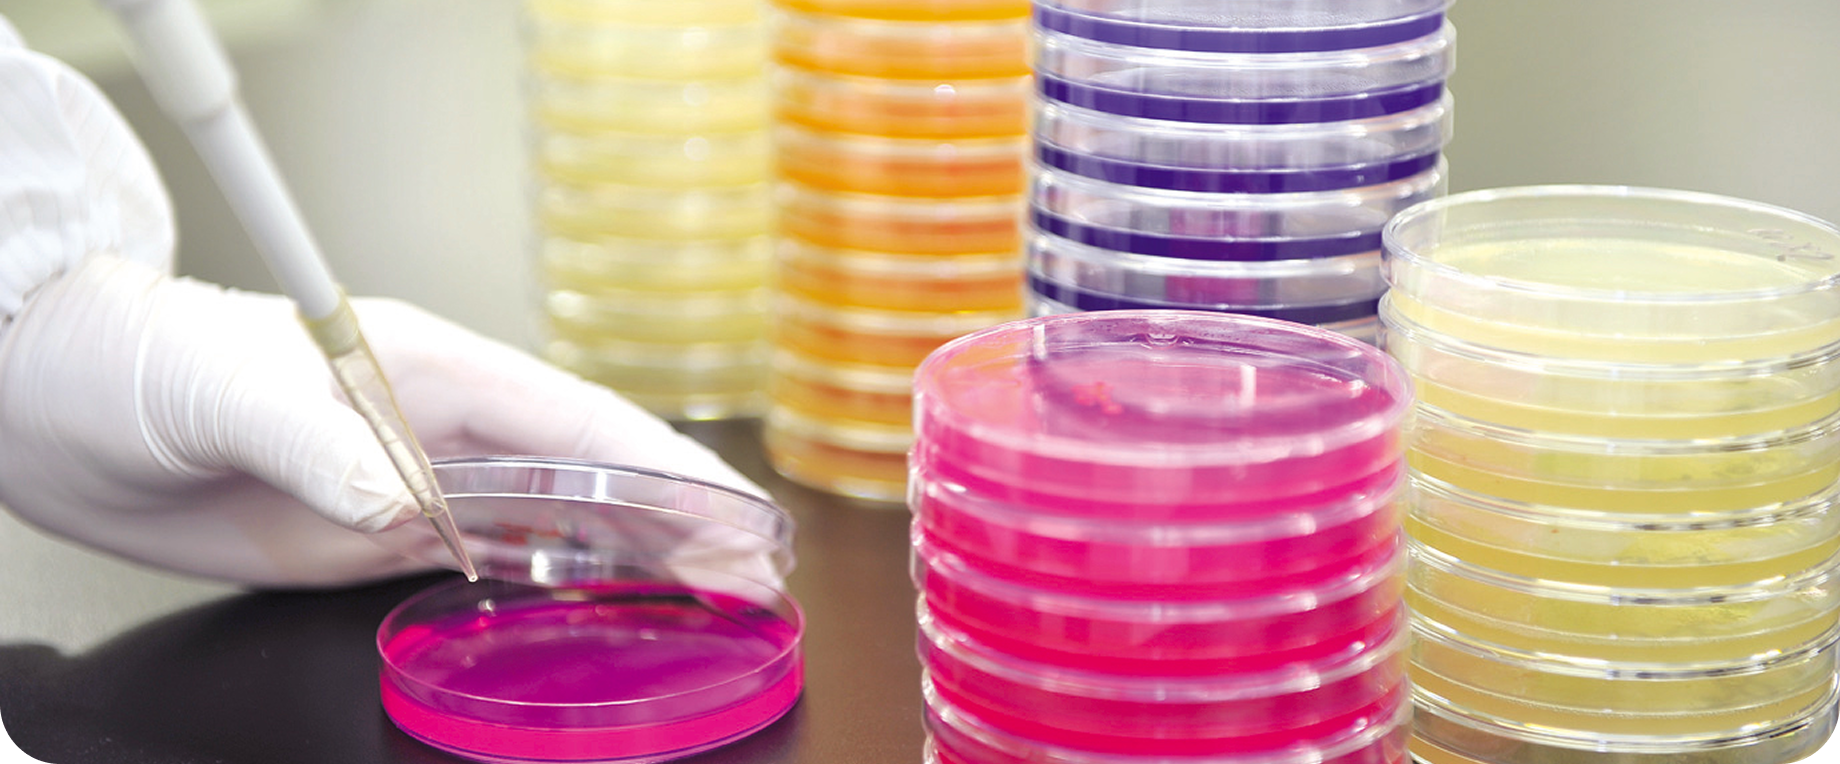

人々の健康と豊かな
生活創りに貢献します
タジマ食品工業は、自然豊かな但馬の地で保健機能食品や医薬品の原料製造を通じ、
「稔り多く」「健やかに」「いきいき」と過ごせるよう、より豊かで充実した人生の実現を目指します。

私たちは、安全・安心な製品づくりを、それぞれの分野で追及しています。
製造工程をご紹介していますので、ぜひご覧ください。


タジマ食品工業では、社員が安心して働くことができるように、さまざまな制度やサポートを用意しています。
-

奨学金返済支援制度
-

技能および
資格取得支援制度 -

人間ドック受診補助制度
-

日本新薬グループ共済会

- タジマ食品工業株式会社
- 〒669-5328 兵庫県豊岡市日高町東芝435 アクセス
- お電話でのお問い合せ

- 受付時間:平日9:00~17:00
(土・日・祝はお休みです)